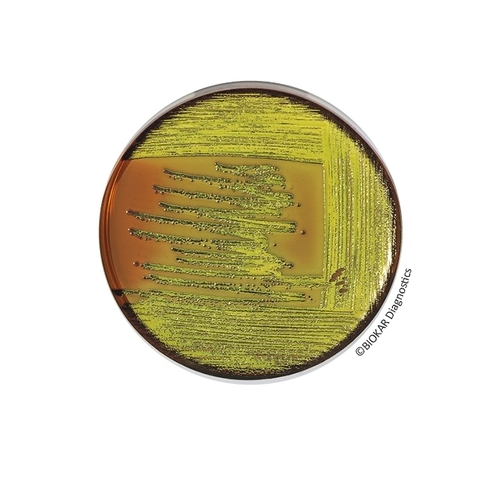
EMB Agar

EMB Agar Levine
EMB Agar, originally recommended by Levine, is used to isolate and identify enterobacteria (notably Escherichia coli and Enterobacter aerogenes) in pharmaceutical, cosmetic and food products as well as water. It is also used as a confirmation media for Escherichia coli in cosmetic products.